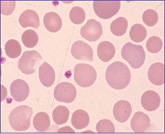
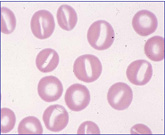
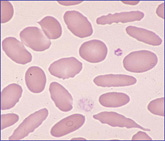
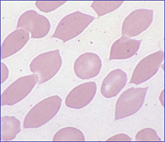
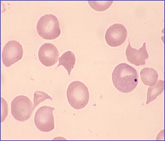

ÔŒŒ‹…Œ`‘Ô‚ÌŒ`ó‚©‚çl‚¦‚é•a‘Ôi‘–¸“dŒ°‚ðŠÜ‚Þj
![]() |
1. ‹…óÔŒŒ‹… spherocyteF’†‰›’W–¾‚ª‚È‚,Œú‚Ý‚ª‘‚µA’¼Œa‚ªŒ¸‚µ¬‰~Œ`ó‚ɂȂéB
|
|---|---|
![]() |
2. —LŒûÔŒŒ‹… stomatocyteF’†‰›’W–¾‚ª’·•ûŒ`‚ɂȂèA‚킸‚©‚ÉŠJ‚¢‚½O‚©‚ç”’‚¢Ž•‚ª‚Ý‚¦‚邿‚¤‚Èó‘Ô‚ð‚¢‚¤B
|
![]() ![]() |
3. ‘ȉ~ÔŒŒ‹… elliptocyteF—‘‰~Œ`, –_ó. ’†‰›’W–¾‚à‘ȉ~‚ ‚è.
ã}‚ÍA³íÔŒŒ‹…‚Ƒȉ~ÔŒŒ‹…‚̬݂ª“Á’¥“I‚ÅA‰º}‚ÍAˆêŒ©‘ȉ~ó‚Å‚ ‚邪•ûŒü‚ª“¯‚¶Œü‚«‚ð’æ‚µ‚Ä‚¢‚邱‚ƂŃA[ƒeƒCƒtƒ@ƒNƒg‚Å‚ ‚é. |
![]() |
4. •W“IÔŒŒ‹… codocyte i codo=bell jF•\–ÊÏ/‘Ìϔ䂪‘‰Á‚·‚é•a‘Ô‚ÅoŒ»‚·‚éBHb‚̇¬áŠQ‚É‚æ‚Á‚Ä‘ÌÏ‚ªŒ¸‚µA‘Š‘Î“I‚É•\–Êωßè‚Æ‚È‚ècodocyte‚ɕό`‚·‚éB
|
![]() ![]() |
5. ƒEƒjóÔŒŒ‹… echinocyteF“Ë‹N‚Ì•ª•z, ’·‚³, ‘¾‚³‚ª‹K‘¥“I‚Åæ’[‚ªë‚éB
|
![]() ![]() |
6. —Lž™ÔŒŒ‹… acanthocyteF“Ë‹N‚Ì•ª•z, ’·‚³, ‘¾‚³‚ª•s‘µ‚¢‚Åæ’[‚ÍŠÛ‚ÝB
|
![]() ![]() |
7. ”jÓÔŒŒ‹… schizocyte ischizo=devidejF¬‚³‚,ˆø‚«—ô‚©‚ꂽ•”ˆÊ‚͉sŠp‚â“Ë‹N‚ðŽ¦‚·Bschistocyte‚Æ‚à•\‹L‚³‚ê‚éB
|
![]() |
8. —Ü“HÔŒŒ‹… dacryocyteFÔŒŒ‹…‚̈ꕔ‚ª‚µ‚Á‚ۂ̂悤‚ÉL‚ї܂̓H‚̂悤‚ɂȂéB‚±‚Ì‚µ‚Á‚Û‚ÍAäB‘Ÿ‚ł̒EŠjŽž‚ɶ‚¶‚½‘Y«•ÏŒ`‚Ì–¼Žc‚Æ‚³‚ê‚éB
|
á‘O‚̃y[ƒW‚Ö–ÚŽŸƒy[ƒW‚ÖŽŸ‚̃y[ƒW‚Öâ